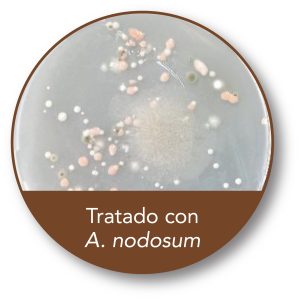
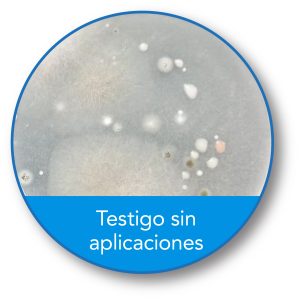

Ascophyllum Ultra•Dry, ventajas de su aplicación al suelo vía riego
Ensayos realizados en Chile con Ascophyllum Ultra-Dry en cultivos de cerezo, nogal y mandarino evidencian mejoras en la calidad del suelo y aumento en la productividad de las plantas.
Ascophyllum Ultra•Dry es un bioestimulante natural, en base a extracto de Ascophyllum nodosum, alga marina rica en aminoácidos, oligosacáricos, vitaminas y nutrientes de alta calidad. Además, contiene betaínas y compuestos de acción auxínica, citocínica y giberelínica, y precursores de estos. Estimula el crecimiento vegetativo, mejora el rendimiento del cultivo y la calidad y condición de los frutos, y es un gran aliado para enfrentar situaciones de estrés abiótico.
• A. nodosum: 960 g/kg
• Materia orgánica: >52%
• Carbono: >30%
Beneficios de la aplicación al suelo de Ascophyllum Ultra•Dry

ENSAYO 1. EVALUACIÓN DE PROPIEDADES FÍSICAS DEL SUELO
• Nogal, Chandler.
• Región Metropolitana
• Aplicación al suelo vía riego, cada 30 días. 4 aplicaciones por tratamiento.
• Evaluación: 20 días después de la 4a aplicación a 15, 45 y 60 cm de profundidad.
• U. de Chile – Agrospec, 22-23.



(1): Análisis factorial de tratamientos y profundidad, letras mayúsculas distintas indican diferencias significativas entre tratamientos para todo el perfil (p ≤0,05).
(2): Letras distintas indican diferencias significativas entre tratamientos para cada profundidad (p≤0,05).
• Densidad aparente: efecto positivo en todas las profundidades.
• Macroporos: mejoró en todo el perfil.
• Humedad aprovechable: diferencias importantes desde los 45 cm de profundidad.
ENSAYO 2. EVALUACIÓN DE MICROORGANISMOS PRESENTES EN EL SUELO

Tratamientos:
Recuento total de microorganismos (3).

Recuento de microorganismos fijadores de nitrógeno (3).

(3): letras distintas indican diferencias significativas entre tratamientos (p≤0,05).
En cerezos y mandarinos, Ascophyllum Ultra•Dry ayudó a la proliferación de microorganismos benéficos y mejoró la relación hongos-bacterias. En mandarinos, con suelos más limitantes, favoreció el desarrollo de bacterias fijadoras de nitrógeno.
Más información en agrospec.cl
